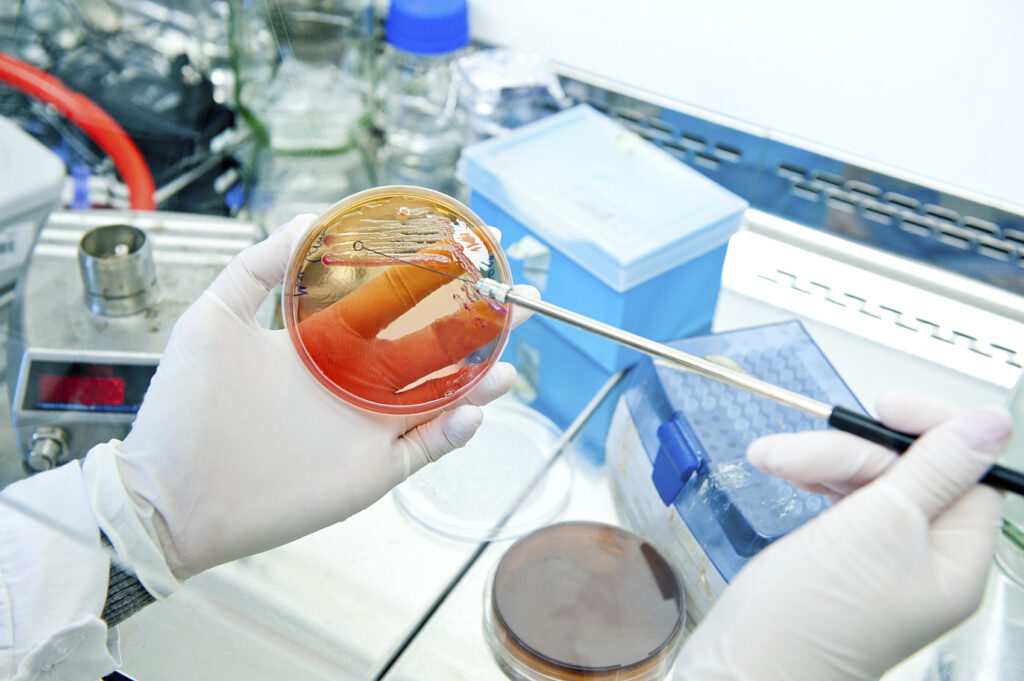

Бак посев на трихомонады сколько дней делается
Трихомониаз — самое распространенное заболевание, предающееся половым путем [1] . Он встречается чаще, чем сифилис и гонорея, вместе взятые [2] . Это заболевание часто протекает бессимптомно и приводит к серьезным осложнениям. Поэтому так важно знать, как вовремя выявить трихомониаз и какие анализы нужно сдать, чтобы его обнаружить.
Трихомониаз — это заболевание мочеполовой системы, которое вызывает небольшое одноклеточное простейшее трихомонада.
Трихомонада — крайне нестойкий организм. Она не переносит высушивания, на влажном белье может сохраняться всего 2–3 часа, и даже водопроводная вода убивает ее всего за несколько минут [3] . То есть заразиться трихомониазом бытовым путем практически невозможно. Для этого обязательно нужен половой контакт.
По данным исследователей, в разных странах трихомонаду выявляют у 2–85% мужчин и 12–65% женщин, которые обратились по поводу уретритов и других воспалительных заболеваний мочеполовой системы. Ученые объясняют такую разницу в показателях точностью лабораторной диагностики трихомониаза [6] .
Если брать российские данные, то трихомонадная инфекция составляет около 34,8% случаев негонококкового уретрита у мужчин и 20–40% обращений среди пациенток гинекологических клиник [7] .
Трихомониаз не всегда вызывает клинически выраженное заболевание. У женщин до половины случаев заражения могут протекать бессимптомно. И выявляется это заболевание уже при обследовании по поводу осложнений — бесплодия, невынашивания беременности, сальпингоофорита, эндометрита [8] . Трихомонады увеличивают риск заражения ВИЧ-инфекцией и риск развития рака шейки матки [9] .
Из-за трихомониаза в половых путях и в уретре развивается воспалительная реакция, появляются микроскопические кровоизлияния. Это нарушает естественный защитный барьер и делает организм более восприимчивым к любым другим инфекциям. Лейкоциты и другие иммунные клетки мигрируют в очаг поражения, где создается их большая концентрация. А именно эти клетки в первую очередь поражает ВИЧ-инфекция. И от того, насколько высока их концентрация в месте соприкосновения с вирусом, зависит вероятность заражения [10] .
Симптомы трихомониаза у женщин — болезненность и дискомфорт внизу живота, которые усиливаются при половых контактах или при мочеиспускании. Появляются выделения желтоватого цвета из половых путей. Часто эти выделения имеют пенистый вид и неприятный запах.
У мужчин появляются слизистые выделения из уретры, боль во время мочеиспускания и половых контактов. Основными осложнениями этой инфекции для мужчин являются простатит и везикулит [11] . В одном из исследований было доказано, что именно трихомонада стала причиной хронического простатита у 29% пациентов [12] .
Российское общество дерматовенерологов и косметологов советует проводить диагностику трихомониаза [13] :
- при воспалительных урологических и гинекологических заболеваниях;
- при обследовании партнеров во время планирования беременности;
- во время самой беременности;
- перед урологическими и гинекологическими операциями;
- при бесплодии;
- после незащищенного полового контакта.
Для выявления трихомонады используют четыре типа методов: микроскопический, культуральный, молекулярно-генетический и серологический. Для того чтобы установить диагноз, достаточно обнаружить этот микроорганизм хотя бы одним из первых трех методов [14] .
Микроскопия — это выявление трихомонады в мазках. Биологический материал наносят на предметное стекло и исследуют его под микроскопом.
Кроме исследования влажного мазка материал могут обрабатывать различными красителями. В этом случае врач ищет под микроскопом клетки определенного размера со специфической окраской и формой.
Этот метод применяют, когда заболевание не сопровождается ярко выраженными симптомами [17] . Его также используют как второй этап диагностики, если микроскопический метод не дал результата. Чувствительность этого метода достигает 95% [18] . Из минусов можно отметить длительность исследования.
Молекулярно-генетические методы — это различные виды ПЦР, NASBA и других реакций, которые выявляют участки ДНК или РНК в биоматериале. ПЦР обладает меньшей чувствительностью, чем культуральный метод, порядка 88–97% [19] . А по некоторым данным — от 55 до 95% [20] .
ПЦР желательно применять вместе с культуральным исследованием. Это значительно повышает вероятность выявления болезнетворного микроорганизма.
Серологическое исследование , то есть определение в крови антител к трихомонаде, используется как дополнение к первым трем методам. Если коротко, то сдать анализ крови на трихомониаз можно, но его результаты нужно оценивать только комплексно с учетом других исследований.
Его недостатком является возможность ложных положительных и ложноотрицательных реакций. Из положительных моментов — антитела сохраняются длительное время, около 1 года после заражения [21] . То есть даже спустя год можно определить, что человек перенес трихомониаз.
Для определения уровня антител понадобится кровь, для проведения всех остальных исследований чаще всего берут соскоб из уретры. У женщин также могут брать материал из влагалища или из цервикального канала — здесь концентрация трихомонад будет самая высокая.
Мужчинам перед взятием анализа на трихомониаз нужно не мочиться около двух–трех часов. Для женщин правил несколько больше. Обследование не проводится во время месячных или накануне, после кольпоскопии или вагинального УЗИ. За 1–2 дня до обследования желательно не использовать свечи, спринцевания и воздержаться от половых актов. Все эти процедуры нарушают состав микрофлоры, и исследование может получиться неточным.
Для проведения ПЦР кроме соскоба можно использовать первую порцию утренней мочи или сперму. Собрать сперму или мочу нужно в специальный стерильный контейнер.
Из всех анализов на трихомониаз самый быстрый — микроскопия нативного мазка. В идеале она должна проводиться через 10 минут после взятия материала. За это время трихомонады не успевают потерять свою подвижность и сохраняют типичную форму [22] . То есть уже примерно через час врач может дать предварительный результат.
В реальности такое возможно в гинекологических или урологических клиниках, при которых есть своя лаборатория с возможностью проводить микроскопическое исследование.
Окрашенные мазки не требуют такой срочности анализа. Поэтому результат будет готов на следующий день или через день.
Результаты ПЦР-исследования обычно можно получить через 1–2 рабочих дня. При обнаружении трихомонад результат могут задержать для постановки подтверждающих проб. Положительный результат выдают при обнаружении этих микроорганизмов, отрицательный — при их отсутствии.
Диагностика трихомониаза культуральным методом — самая долгая. Она может занимать более недели. За это время исследуемый материал помещают на питательную среду, следят за ростом микроорганизмов на ней, проводят повторное определение возбудителя. Идеальный вариант — отсутствие роста. Это означает, что в собранном материале не было живых трихомонад. Если, конечно, были точно соблюдены все требования по забору биоматериала, его хранению и транспортировке. Положительный результат анализа на трихомониаз говорит о заражении.
Анализ крови на трихомониаз проводится в течение 1–2 рабочих дней. Положительный результат говорит о том, что в крови есть антитела, то есть пациент или болеет трихомониазом, или перенес его в прошлом. Отрицательный результат — отсутствие заболевания или низкий уровень антител. Сомнительный — это пограничный результат, который сложно интерпретировать. В таком случае обычно рекомендуют повторить исследование через 1–1,5 недели.
Стоимость анализа на трихомониаз зависит от метода исследования и метода забора материала. Например, в Москве стоимость забора мазка из уретры или из влагалища — около 400 рублей. За взятие крови возьмут 150–200 рублей. А при сдаче мочи или спермы доплачивать не придется, стоимость контейнера обычно уже включена в цену исследования.
Микроскопия мазка будет стоить от 450 до 600 рублей в зависимости от лаборатории. ПЦР-исследование — 300–450 рублей вне зависимости от вида материала. Анализ на трихомониаз культуральным методом выполняется не во всех клиниках и стоит от 800 до 1300 рублей [24] . А серологическая диагностика трихомониаза по крови обойдется примерно в 600–800 рублей.
Трихомониаз — это венерическое заболевание, которое часто протекает бессимптомно и является причиной серьезных осложнений. Лабораторная диагностика трихомониаза позволяет выявить это заболевание даже в стертой форме и вовремя начать лечение. А лучшей профилактикой любых половых инфекций остается использование барьерных методов контрацепции.

Отказ от случайных половых связей и защищенный секс — вот лучшие методы профилактики трихомониаза и других ИППП. Но если заражение все же произошло, стоит точно соблюдать схему лечения и по окончании терапии пройти контрольный анализ. Кстати, сейчас во многих частных клиниках комплексную диагностику ИППП можно пройти анонимно.
Анализ на трихомониаз назначается пациентам, имеющим признаки инфекционного заболевания мочеполовой системы. Согласно статистическим данным, у более 50% мужчин и женщин, обратившихся по поводу уретрита, эндометрита и других патологий, в ходе лабораторного исследования были выявлены Trichmonas vaginalis. Эти патогенные бактерии паразитируют в человеческом организме и вызывают воспалительные процессы в органах и системах. Трихомониаз передается преимущественно половым путем, но существует вероятность развития заболевания при бытовых контактах.

Какие анализы сдают на трихомониаз
Анализ проводится несколькими методами:
- Микроскопический. В качестве биологического материла для исследования используются выделения, собранные со слизистой влагалища, уретрального канала, кишечника. Диагностика проводится вскоре после забора жидкости, поскольку через час и более трихомонады начинают погибать, что снижает вероятность их обнаружения. При процедуре исследования лаборант может применять цветные реагенты, помогающие определить клетки паразитов и отличить их от других микроорганизмов.
- Микробиологический. Способ основан на подселении трихомонад на питательные среды. Бак посев проводится после микроскопического исследования. Этот метод отличается высокой информативностью, но занимает длительное время.
- Молекулярно-генетический. В условиях лаборатории осуществляется исследование с применением NASBA-теста, ПЦР (полимеразно-цепной реакции). Метод основан на выявлении участков РНК и ДНК в биологических материалах. В отличие от культурального метода молекулярно-генетический обладает менее высокой чувствительностью, поэтому для постановки правильного диагноза используются оба вида исследования.
- Серологический. В лабораториях проводится анализ крови, в ходе которого обнаруживаются иммуноглобулины, вырабатываемые организмом человека в ответ на внедрение патогенных бактерий. Серологическая диагностика может приводить в ряде случаев к получению ложноотрицательных или ложноположительных результатов, что связано со способностью трихомонад вступать в реакции с белковыми образованиями человеческого организма. Метод применяется для подтверждения диагноза в сочетании с другими лабораторными исследованиями.
Все виды диагностики заболевания, кроме серологического, проводятся с применением мазка.
Кроме исследования соскоба и крови требуется проведение анализа мочи, у представителей сильного пола — спермы. Комплексный подход позволяет выявить инфекционное заболевание и назначить правильное лечение.
Как подготовиться к сдаче анализа
От правильности подготовки к сдаче биологического материала зависит достоверность полученных в ходе исследования данных.

Перед проведением соскоба женщины должны придерживаться следующих правил:
- посещать гинеколога в период отсутствия менструации или через 5-6 дней после того, как закончится кровотечение;
- не сдавать анализы после проведения ультразвукового исследования вагинальным методом;
- за 4-5 суток не рекомендуется применять любые суппозитории, спринцеваться антисептическими лекарственными и травяными растворами;
- накануне соскоба женщина должна избегать полового контакта.
При несоблюдении рекомендаций возможно получение неправильных результатов лабораторных исследований из-за нарушения микрофлоры влагалища.
Мужчина также должен придерживаться определенных правил:
- За 2 часа до забора биоматериала нужно не допускать мочеиспускания.
- За 1-2 дня необходимо отказаться от интимных контактов.
Подготовка к серологическим анализам также требует соблюдения рекомендаций, с которыми накануне должен ознакомить врач. Для того чтобы результаты были достоверными, за пару дней до сдачи крови пациенты должны избегать употребления жирной пищи, алкоголя. Утром перед исследованием нельзя курить, пить напитки, содержащие кофеин, соки, лимонад. Допускается прием малого количества чистой питьевой воды.
В некоторых случаях возможна провокация медикаментозными средствами, направленными на снижение иммунитета и активизацию возбудителя.
Как берут
Взятие венозной крови, мочи, семенной жидкости осуществляется утром. Контейнер для анализов необходимо подготовить заранее. Он должен быть стерильным и герметичным. Урина, сперма собирается дома. Мазок на микрофлору осуществляется при осмотре у гинеколога.
Кровь из вены сдается натощак, с 8 до 11 часов. Процедуру проводят с применением одноразового шприца или вакуумной системы, состоящей из пробирки с химическими реактивами, иглы и устройства-держателя. Пациент располагается на стуле рядом с медицинским столом. Его рука фиксируется с поднятой вверх ладонью с помещением локтя на специальный валик. После наложения жгута и обработки поверхности кожи ватным тампоном со спиртом медицинский работник вводит иглу в вену. По окончании забора крови пациент должен согнуть руку на несколько минут вместе со стерильным бинтом, смоченным в антисептике.
Сколько делается и действует анализ на трихомониаз
Трихомонадный анализ мазка с применением микроскопического метода осуществляется в течение 60 минут.
Этот вид исследования проводится в кратчайшие сроки после забора биологического материала, иначе патогенные микроорганизмы начинают гибнуть без наличия благоприятных условий.
Данные с применением молекулярно-генетического метода обычно получают в течение 2 рабочих дней. Микробиологическая диагностика занимает больше времени. Результаты выдаются пациентам в среднем через 1-2 недели. Помимо трихомонады в мазках могут быть выявлены дрожжевые грибки, гарднереллы и другие патогенные бактерии.
Анализы, полученные с применением полимеразно-цепной реакции, обычно готовятся 2 дня. Если трихомоноз обнаружен, результаты могут быть задержаны для осуществления подтверждающей пробы.
Анализ годен в течение 1-3 месяцев. Уточнить о том, сколько действует результат, лучше у лечащего врача.
Расшифровка: нормы и отклонения
Обнаружение IgG при отсутствии IgM означает, что инфекционное заболевание, вызванное трихомонадами, перешло в хроническую форму без наличия активности. При выявлении иммуноглобулинов класса M и не обнаружении антител G можно говорить о недавнем заражении и остром течении. Выявление сразу двух видов антител свидетельствует о периоде обострения хронической инфекции.
В некоторых случаях возможно получение сомнительного результата лабораторного исследования. При получении пограничных данных врачи рекомендуют сдать анализ повторно через 10 дней.
Когда сдавать анализы после лечения трихомониаза
После проведенной медикаментозной терапии важно подтвердить факт излечения заболевания. Это необходимо для:
- возврата к половой жизни, от которой рекомендуется воздержаться на период приема антибактериальных препаратов;
- предотвращения риска возникновения осложнений, нередко возникающих при затяжной форме трихомониаза и проявляющихся воспалением органов половой и мочевыводящей систем;
- исключения скрытого течения инфекционного заболевания.
Некоторые врачи считают, что контрольные анализы необходимо проводить после окончания терапии только бессимптомных форм трихомониаза. После лечения пациентов с выраженными симптомами инфекции, которое привело к полному исчезновению всех признаков болезни, считается, что повторные исследования можно не проводить.
Другие медики придерживаются старых принципов и назначают сдавать биоматериал для контрольных анализов после завершения лечения любых форм трихомониаза. Для того чтобы удостовериться в полном отсутствии патогенных микроорганизмов, пациентам рекомендуется пройти повторные исследования 3 раза с интервалами в 30-60 дней.
При получении отрицательных результатов можно говорить о полном излечении инфекционного заболевания.
Стоимость анализа и где сдать

Анализы на трихомониаз можно сдать в следующих лабораториях:
- Инвитро. Исследования проводятся методом ИФА и занимают 5 рабочих дней. Стоимость — 12,54 $. Цена процедуры взятия биоматериала составляет 3,5$.
- Синево. Анализы крови с выявлением иммуноглобулинов IgG выполняются в течение 3 рабочих дней и стоят 8,4$.
- Центр молекулярной диагностики CMD. Услуги по исследованию биологического материала с определением РНК методом NASBA стоят 25,1$. Срок выдачи результатов — через 1-2 дня. Стоимость анализа с качественным определением ДНК составляет 5,6$. Цена на количественный метод — 7,4$. Результаты предоставляются в течение 1-3 дней.
Исследования биоматериала на трихомониаз проводятся с использованием сразу нескольких лабораторных методов. Комплексные диагностики, включающие серологические, иммуноферментные, микроскопические и культуральные анализы, позволяют врачам поставить точный диагноз и правильно подобрать медикаментозные препараты. Если результат ложноположительный или сомнительный, назначаются повторные исследования. Достоверность данных зависит не только от квалификации работников лаборатории и качества реактивов, но и от соблюдения пациентами правил подготовки к сдаче биологического материала.

Методика хорошо изучена, подходит для обследования пациентов обоих полов и любого возраста. По чувствительности, примерно в 2 раза превосходит классическую микроскопию.
Посев на трихомонады: на чем основана методика?
Как и любое культуральное исследование, бак посев на трихомонады заключается в том, что к специальной питательной среде добавляется небольшое количество биологического материала, полученного из очага инфекции.
Пробу затем ставят в термостат на культивацию при оптимальной для размножения микробов температуре. Если в образце имеются жизнеспособные микроорганизмы, то в благоприятных условиях они начинают размножаться.
Формируются колонии, заметные невооруженным взглядом. Наличие таких изменений на питательной среде однозначно указывает на то, что пациент заражен трихомонадами.
Какие условия нужно создать?
Возбудитель трихомоноза (Trichomonas vaginalis) является особенным микроорганизмом. По своей сути это – не бактерия, а одноклеточный паразит.

Он не способен синтезировать некоторые нужные вещества и предпочитает получать их от эпителия мочеполовых путей.
Отсюда, для анализа на трихомонады условия для посева должны соответствовать ряду требований:
- В состав питательного субстрата необходимо включать особые белки, липиды и витамины.
- рН в районе 6.0-6.3.
- Отсутствие доступа воздуха.
- Температура 35-37˚С.
- Требуется примесь антибиотиков (пенициллин, доксициклин и др.) для подавления роста сторонней флоры.
Практика показала, что проще всего такие условия создать в жидкой среде – бульоне.
Приготовление субстрата и дальнейшая культивация требуют особых условий. Так что посев на трихомонады рекомендуется сдавать в специализированных кабинетах и диспансерах. Там, где где имеется соответствующее оборудование или быстрый доступ к возможностям баклаборатории 2 – 3 уровня.

Trichomonas vaginalis в основном поражают органы мочеполовой системы, но могут достаточно активно размножаться и в других отделах тела.
Поэтому собирать диагностический материал требуется с разных мест:
- Уретра (мазок, соскоб).
- Задний свод влагалища.
- Шейка матки.
- Сок простаты.
- Мазок с зева.
- Ампула прямой кишки.
- Конъюнктива глаз.
Место забора материала зависит от локализации трихомоноза. Как правило, сбор проб на выявление трихомонад проводит тот же врач, который и назначает анализы: дерматовенеролог, уролог, иногда – гинеколог.

Способ, как собирают материал для посева, зависит от места, откуда берут пробу. Для цервикального канала нужна специальная щеточка, для уретры – тонкий стерильный зонд, с конъюнктивы – стерильный тампон.



С момента своего появления, методика бактериологического исследования непрерывно совершенствуется. На начало XXI века чувствительность посева на трихомонады стала очень высока.
Для получения положительного результата достаточно, чтоб в 1 мл материала содержалось 300 жизнеспособных микробных тел. По данным разных авторов, точность результатов достигает 96,2%.
В сравнении с посевом, другие распространенные методы диагностики трихомонад показывают:
- Микроскопия – примерно 45% точных диагнозов.
- Иммуноферментный анализ (ИФА) – 43,5%.
- Полимеразно-цепная реакция (ПЦР) – 94-97%.
- Латекс-агглютинационный тест – около 70%.
Как видно, конкуренцию посеву может составить только молекулярно-генетическая методика.

Но для максимально точного результата, необходимо, чтоб сбор диагностического материала проводил профессиональный специалист.
Особая внимательность нужна при обследовании мужчин: у них количество трихомонад не столь обильно, как у женщин. Поэтому для полноценного исследования рекомендуется брать сразу несколько проб с разных мест.

Чтоб снизить вероятность ложноотрицательных результатов, разработан ряд рекомендаций:
- Собирать мазок и соскоб минимум с 2-3 участков пораженных органов разными одноразовыми зондами, если это уретра – то с разной глубины.
- Ставить пробы на культивацию в течение 2 часов с момента сбора.
- Брать анализы на посев только по истечении 5-7 дней после приема антибиотиков и противоцистоцидных препаратов.
- Проводить исследование несколько раз – минимум дважды накануне лечения, в процессе терапии, и дважды для контроля выздоровления после лечения.
Все эти нюансы квалифицированный врач рассказывает своим пациентам тогда, когда назначает посев в рамках диагностики трихомонад. Также необходимо учитывать, что трихомонады часто сочетаются с другими возбудителями урогенитальных инфекций.

Например – гонококками, поэтому для их выявления в питательную среду могут не добавлять пенициллин или другие антибиотики.
Несмотря на высокую точность и чувствительность методики, бактериологический метод (или посев) не лишен своих недостатков:
- Есть вероятность ошибки при сборе проб.
- Сроки изготовления результатов составляют 5-7 дней.
- Интерпретация данных заключается только в факте наличия или отсутствии трихомоноза.
- От момента заражения до нарастания диагностически значимой микробной массы проходит несколько недель, если в этом периоде сдать анализ – посев будет отрицательным.

Но, при наличии у пациентов эпизодов неудачи лечения, посев на трихомонады может помочь выявить резистентность микроорганизмов к применяемым препаратам. Именно эта уникальная особенность позволяет анализу оставаться востребованным даже спустя более 50 лет от своего первого использования.
При подозрении на трихомонаду обращайтесь к грамотным венерологам.
Бак посев на трихомонады. При обнаружении трихомонад в мазке пациенту ставится диагноз трихомониаз или трихомоноз. Это воспалительное заболевание мочеполовой системы встречается не только у женщин, но и у мужчин. Среди всех венерических болезней трихомониаз получил особенно широкое распространение, поэтому следует узнать причины этой патологии и устранить все факторы риска. Трихомониаз — весьма распространенное заболевание, которое передается половым путем. Бак посев на трихомонады — один из современных методов диагностики заболевания.
Трихомониаз (Трихомонада)

Очень часто трихомониаз ошибочно называют триппер, но это не так. Триппер — это гонорея, другое воспалительное заболевание мочеполовой сферы, вызываемое гоноккоком. Трихомониаз передается половым путем — это не только традиционные контакты, но и оральные и анальные.
Инкубационный период 3-5 дней (от момента заражения и до появления первых признаков заболеваний), но учитывая нашу эру антибиотиков и противомикробных препаратов, также необоснованное их назначение, мне приходилось консультировать больных, когда трихомоноз затягивался и до 3 недель.
Симптомы трихомониаза
Первые симптомы заболевания — это пенисто-слизистые выделения у мужчин и женщин, рези при мочеиспускании, зуд в уретре, влагалище. Довольно часто при присоединении других микроорганизмов, т.е сопутствующей инфекциии, может появляться и гной. Но я уже писала выше, что трихомониаз — это уникально-коварное, малоизученное заболевание.
Попадая в организм, этот паразит начинает выделять вещества, которые подавляют нормальный иммунный ответ человека.
Диагностика трихомониаза у женщин
Бак посев на трихомонады. Во время первого же осмотра в зеркалах врач берет так называемый общий мазок для бактериоскопического исследования. Для анализа на трихомониаз берут выделения из заднего свода влагалища. Лучше, если этот анализ делается немедленно – биение ресничек трихомонады и высокая подвижность овальных микроорганизмов хорошо заметны под микроскопом, а результат исследования готов уже через 20 минут.
Этот вид диагностики позволяет установить общее количество микробов и степень выраженности воспалительной реакции.
Если мазок исследуют после высушивания и окрашивания, то результат чаще всего отрицательный, т.к. трихомонада при высушивании теряет свою подвижность и специфическую анатомию. При этом возможны диагностические ошибки, поскольку клетки эпителия влагалища могут быть приняты за трихомонады.

Наиболее точным методом на настоящий момент считается полимеразная цепная реакциядля определения ДНК трихомонады (ПЦР). Точность этого исследования составляет около 95%, а делается анализ за 1-2 дня.
В сомнительных случаях при диагностике трихомоноза дополнительно может использоватьсяметод прямой иммунофлюоресценции (ПИФ) для выявлении антител к возбудителю инфекции в крови больного.
Анализы на трихомониаз

Иногда доктор, когда нужно минихирургическое вмешательство (например прижигание эрозии шейки матки) или исследование (уретроскопия-аппаратное исследование уретры), может назначить консультацию гинеколога или уролога.
Какие анализы придется сдавать? Однозначно — это мазки. Мужчины из уретры, женщины из влагалища и уретры. Лучше всего, если сильный пол придет к врачу с утренней задержкой мочи (вечером помочиться, а утром не мочиться).
В этом случае обнаружить его бывает очень нелегко. Часто приходится сталкиваться с пациентами, которые обращаются с осложнениями трихомониаза и у которых повышенные лейкоциты в мазке (клетки, отвечающие за защитную функцию организма), но трихомонады не выявлены ни в одном мазке. Тут и приходит на помощь старая, добрая провокация… Заключается она в том, чтобы резко снизить иммунитет пациента и создать благоприятные условия для трихомонад, чтобы выявить их в анализах.
Анализы при подозрении на урогенитальную инфекцию, в том числе трихомониаз:
- общий анализ крови
- общий анализ мочи
- бактериоскопический анализ выделений (мазок)
- ПЦР диагностика
- посев с определением чувствительности к антибиотикам и противогрибковым препаратам
Основной метод диагностики трихомониаза — это оценка гинекологом симптомов трихомониаза во время гинекологического осмотра и результата анализа мазка из влагалища.

Выявлению сопутствующей трихомониазу условно-патогенной флоры помогает посев выделений из влагалища на дисбактериоз с одновременным определением чувствительности флоры к антибиотикам. Для общей оценки заболевания также рекомендуется проведение исследований на хламидии, микоплазмы, ВИЧ, гепатиты и другие инфекции передающиеся половым путём, которые часто выявляются при трихомониазе.
Наиболее информативными являются анализы выделений из влагалища — ПЦР-диагностика трихомониаза. ПЦР — метод молекулярной диагностики ИППП, в том числе трихомониаза, проверенный временем. Метод ПЦР позволяет определить наличие возбудителя трихомониаза, даже если в пробе присутствует всего несколько молекул ДНК микроорганизма. Точность анализа ПЦР при правильном выполнении достигает 100%. Метод ПЦР диагностики ЗППП позволяет выявлять даже единичные клетки бактерий или вирусов. ПЦР диагностика обнаруживает наличие возбудителя трихомониаза в тех случаях, когда при помощи других анализов это сделать невозможно.
Особенно эффективен анализ ПЦР для диагностики скрыто существующих форм микроорганизмов, в том числе уреаплазм, с которыми часто приходится сталкиваться при бессимптомных и хронических ЗППП.
При помощи анализа ПЦР определяют возбудителя трихомониаза, а не реакцию на его внедрение со стороны организма. Таким образом, трихомониаз возможно диагностировать еще в инкубационном периоде и при скрытом его течении, когда нет никаких клинических или лабораторных симптомовтрихомониаза.
Но даже ПЦР диагностика трихомониаза — не идеальный анализ. Это очень высокотехнологичный метод исследования, требующий соблюдения строжайших правил оснащения лаборатории. Образец материала для любого анализа должен брать квалифицированный врач, строго следуя инструкции, которую ему дает лаборатория. Оценивать результаты анализа ПЦР должен врач, который лечит конкретного больного.
Не всегда положительный результат анализа ПЦР означает наличие трихомониаза. Возможны ложноположительные результаты анализа если:
![]()
Не всегда положительный результат анализа ПЦР означает наличие трихомониаза- после курса лечения от уреаплазмоза погибший и уже не опасный возбудитель инфекции выводиться из организма иммунной системой
Бак посев на трихомонады. Возможны ложноотрицательные результаты анализа даже при наличии явных симптомов урогенитальной инфекции. Возможные причины такого результата анализа:
- материал для анализа был взят или исследован неудачно
- женщина менее чем за месяц до сдачи анализа принимала антибиотики, или использовала свечи, спринцевания
- не было учтено, что перед забором материала из уретры нельзя мочиться в течение 1 часа
- отсутствие генома микроорганизма в образце материала (в выделениях) при локализации воспалительного процесса в глубоких отделах половой системы (яичники, маточные трубы, предстательная железа)
Анализ ПЦР — мощный и эффективный диагностический инструмент, позволяющий быстро и точно найти возбудителей очень многих ЗППП. Чаще всего его используют для диагностики именно инфекций, передающихся половым путем. В любом случае нельзя ограничиваться только одним анализом. Лучше всего комбинировать различные анализы и сдать их несколько раз при сомнительных результатах.
Кроме определения самого возбудителя инфекции методом ПЦР диагностики необходимо оценивать и иммунный ответ организма, который определяется серологическими методами, например, ИФА.
Общая информация об исследовании
Бак посев на трихомонады. Урогенитальный трихомониаз (трихомоноз) – это широко распространенное инфекционное заболевание мочеполовой системы, передающееся преимущественно половым путем. Его возбудителем является простейшее Trichomоnas vaginalis. Наиболее часто поражается уретра и влагалище (у женщин). Источник инфекции – больной трихомониазом. Основной путь передачи – половой.
Инкубационный период у женщин составляет 5-28 дней. Признаки заболевания у них часто появляются (или усиливаются) при наступлении менструаций: пенистые желтоватые выделения из влагалища, зуд и жжение в нем и в области вульвы, боль при мочеиспускании и при половом акте. Нередко инфекция протекает бессимптомно. При беременности трихомониаз может быть причиной низкого веса новорожденных или преждевременных родов.
У мужчин трихомониаз сопровождается постоянными белыми выделениями из уретры, однако часто симптомы отсутствуют. Изредка трихомониаз вызывает баланопостит, простатит, эпидидимит, цистит.
- Чтобы установить причину воспалительных заболеваний мочеполовой системы.
- Чтобы выявить трихомониаз или подтвердить диагноз.
- Для дифференциальной диагностики (наряду с другими исследованиями) заболеваний, протекающих со сходными симптомами, таких как гонорея, хламидиоз, микоплазменная, уреаплазменная инфекция.
- При симптомах трихомониаза и отрицательных результатах микроскопии.
- При хронических воспалительных заболеваниях мочеполовой системы.
- При положительных результатах серологического исследования.
- При планировании беременности.
- Если известно, что у пациента случаются беспорядочные половые связи.
Бак посев на трихомонады

Трихомониаз является заболеванием органов мочеполовой системы, вызываемым простейшим одноклеточным паразитом Trichomonas vaginalis, более известным как трихомонада. Заболевание относится к ЗППП, редкие случаи указывают на вероятность заражения через общие предметы быта либо при посещении общественных бань, соляриев и т. п. Одним из самых эффективных методов диагностики трихомониаза в наше время является бак посев на трихомонады. Бакпосев, проводящийся в лабораторных условиях, подразумевает забор у пациента биологического материала, который потом помещается в специальную питательную среду. Дальнейший ход исследования заключается в выращивании и исследовании трихомонад на чувствительность к антибиотикам различных групп.
Трихомониазу в 75% случаев заболевания сопутствует разнообразная бактериальная флора, при этом до 40% таких пациентов заражены одновременно и микоплазмозом. Если не делать бакпосев на трихомонады, большая часть таких пациентов будет определена в группу бактериальных уретритов.
Кроме того, многократно фиксировались случаи, когда даже после эффективного лечения в организме пациентов появлялись урогенитальные трихомонады круглых форм. У отдельных экземпляров выделяли до 3-5 ядр, отмечали отсутствие жгутиков и ундулирующей мембраны.
Ученые рассматривают паразитов такой формы как прохождение одного из этапов самосохранения этих простейших. Доказано, что их появление может привести к рецидиву заболевания, но диагностировать их только с помощью микроскопии мазка, не делая бак посев на трихомониаз, вряд ли получится.
Помимо возможности самосохранения трихомонад в организме пациента, прошедшего курс лечения, не исключена и возможность повторного заражения. По этой причине пациентам, имеющим постоянного полового партнера, настоятельно рекомендуется проходить курс лечения вместе с ним. Варианты лечения может подобрать только врач и только после получения результатов всех необходимых анализов.
Лечение трихомониаза

Бак посев на трихомонады. Основная группа препаратов в лечение трихомоноза — это 5-нитромедазолы (трихопол, метрогил, тиберал..). Нужно учесть, что дозы приема препарата, указанные на упаковке, малы и малоэффективны. Для лечения сопутствующей инфекции применяют антибиотики широкого спектра действия (юнидокс, азитрокс и т.д). При хронической форме присоединяются иммуномодуляторы (пирогенал, иммунал….), рассасывающие препараты (Лидаза, трипсин, вобензим), препараты, улучшающие
флору кишечника (хилак-форте, нормаза…). Местное лечение в виде ванночек и вливаний в уретру (хлоргексидин,мирамистин….).
Половая жизнь и употребление спиртного во время лечения строго запрещены. Целесообразно после лечения, особенно хронической формы трихомоноза, пройти курс лечения препаратами, улучшающими микрофлору кишечника. Человек считается излеченным от трихомониаза, если не обнаружены трихомонады у женщин — в течение 2 месячных циклов, у мужчин через 2 недели после лечения и также через месяц.
Читайте также:



